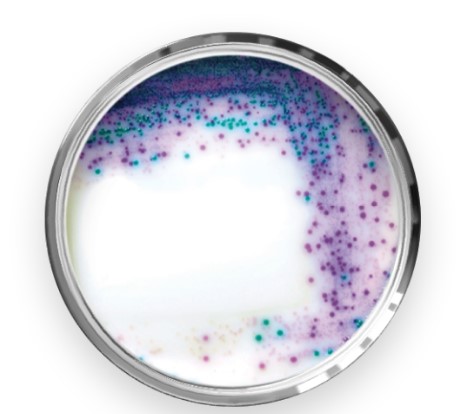

Buletin Warung Sciencewerke: Rubrik Mikrobiologi
Yuk Kenalan Sama Media RAPID’Salmonella Agar: Satpamnya Salmonella spp. Pada Isu Keamanan Pangan.
Oleh: Imam Hardiman, MSc.

Bakteri Salmonella adalah salah satu bakteri patogen yang paling sering menjadi penyebab keracunan makanan (red. foodborne illness). Kehadirannya dalam pangan sangat berbahaya karena dapat menimbulkan infeksi serius, terutama pada kelompok rentan seperti anak-anak, lansia, ibu hamil, dan orang dengan daya tahan tubuh yang lemah. Beragam sumber kontaminasi Salmonella bisa berasal dari produk hewani mentah seperti daging unggas, telur, ataupun susu yang tidak dipasteurisasi. Selain itu, produk nabati seperti sayuran, buah-buahan ataupun rempah-rempah yang terkontaminasi juga dapat menjadi sumber cemaran Salmonella pada makanan yang kita konsumsi. Selain bersumber dari bahan baku pangan, kontaminasi silang Salmonella juga dapat terjadi saat peralatan dapur ataupun tangan yang kotor menyentuh makanan yang siap saji. Hal ini bisa terjadi di dapur umum ataupun dapur-dapur yang menyediakan makanan siap saji terutama dalam jumlah yang besar.

Gambar
SEQ
Gambar \* ARABIC
1
Ilustrasi Kontaminasi Salmonella
dengan
Kaitannya
terhadap Keamanan Pangan.
Sumber Gambar:
Kompasiana.com
Baca Juga: Kabar Lingkungan Sciencewerke: Scientific Environmental Investigation

Gambar 2 Media Siap Pakai Rapid'Salmonella Ager #3563961
Salah satu program unggulan Presiden Prabowo Subianto adalah program Makan Bergizi Gratis (MBG) yang resmi diluncurkan sejak tanggal 06 Januari 2025 lalu. Hingga bulan Juli kemarin sudah lebih 2,100 Satuan Pelayanan Pemenuhan Gizi (SPPG) aktif yang senantiasa menyediakan makanan bergizi bagi para pelajar dari jenjang PAUD (Pendidikan Anak Usia Dini) hingga ke SMA (Sekolah Menengah Atas). Dikarenakan banyaknya jumlah mekanan yang perlu dikelola untuk setiap dapur SPPG, maka banyak tantangan yang dihadapi dalam program ini, salah satunya adalah adanya insiden keracunan makanan. Per bulai Mei 2025 saja, sudah terdapat laporan 17 insiden keracunan makanan yang melibatkan 1,602 orang dalam program MBG ini (Sumber Laporan: Merdika.id). Guna memastikan keamanan makanan yang didistribusikan dalam program MBG ini, dilakukanlah integrasi program Inspeksi Kesehatan Lingkungan (IKL) yang mana diantaranya adalah pemeriksaan higiene sanitasi tempat pengolahan makanan (red. dapur), pengujian kontaminasi mikroba (red. salah satunya adalah bakteri Salmonella spp.), dan pemantauan penyiapan dan distribusi makanan. Adapun standar keamanan pangan yang diimplementasikan adalah berdasarkan SNI 7388 (red. untuk batas cemaran mikroba) dan Permenkes No. 1096/2011 (red. untuk higiene sanitasi jasaboga).
Media RAPID’Salmonella Agar sebagai salah satu media kromogenik buatan BioRad Laboratories. hadir memberikan solusi alternatif dalam pengujian cemaran Salmonella spp. Dengan menggunakan media RAPID’Salmonella agar, pengerjaan pendeteksian cemaran Salmonella spp. yang biasanya membutuhkan waktu sekitar 5 hari (red. bila pengujian hasilnya positif) kini hanya membutuhkan waktu hanya 2 hari saja (red. sampai uji konfirmasi). Bukan hanya memberikan hasil yang lebih cepat saja, akan tetapi media ini juga menawarkan solusi dengan kebutuhan media yang relatif lebih sederhana karena hanya membutuhkan 1 media pengkayaan (red. Buffer Peptone Water/BPW) dan 1 media pendeteksian (red. media RAPID’Salmonella Agar). Hal ini dikarenakan konsep yang diusung oleh Biorad adalah One Broth One Plate. Apalagi didukung pengujian konfirmasi yang cukup cepat (red. kurang dari 5 menit) dan berbasis serotyping yaitu dengan Salmonella Latex.

Di dalam pengerjaannya, interpretasi pengujian Salmonella menggunakan media RAPID’Salmonella agar yang kita lakukan juga cukup mudah. Hal ini karena bahan kromogenik yang terkandung di dalam media ini bisa menghasilkan perbedaan warna yang cukup signifikan antara warna koloni Salmonella spp. yang menghasilkan warna magenta dan bakteri Enterobacteriaceae lainnya yang berwarna biru-hijau. Reaksi warna ini adalah hasil aktivitas dari substrat kromofor dengan enzim C8 esterase dan β-D glucosidase. Dengan perbedaan warna yang cukup signifikan ini membuat interpretasi hasil menjadi lebih mudah, akurat dan objektif.
Baca Juga: Pojok Halal Sciencewerke: Scientific Halal Investigation (Jilid 2)
Selain itu dalam kaitannya dengan regulasi, pengujian Salmonella menggunakan media RAPID’Salmonella agar ini juga sudah tervalidasi terhadap ISO 16140-2 yang menjadikannya dapat digunakan sebagai metode alternatif dalam pengujian Salmonella spp. pada sampel pangan, pakan, dan lingkungan terhadap referensi metode baku ISO 6579-1. Dengan tervalidasinya terhadap ISO 16140-2 membuat setiap laboratorium yang mau beralih menggunakan media ini tidak perlu melakukan validasi ulang. User cukup melakukan verifikasi metode saja untuk memastikan operator/user laboratorium dapat melakukan pengujian menggunakan media RAPID’Salmonella agar ini secara baik dan benar. Di sisi lain, media RAPID’Salmonella agar ini juga sudah tersertifikasi oleh lembaga sertifikasi internasional seperti AOAC, AFNOR (NF Validation), dan NordVal. Dengan semua referensi tersebut membuat implementasi media RAPID’Salmonella agar ini lebih memudah kan dalam proses akreditasi laboratorium pengujian untuk mengimplementasikan ISO 17025.
Dalam kaitannya dengan program MBG atau lebih tepatnya implementasi program IKL pada dapur-dapur SPPG, penggunaan media RAPID’Salmonella agar ini sangatlah memenuhi kriteria dalam penggunaannya. Selain menawarkan metode yang lebih cepat dan praktis, media ini juga sudah tervalidasi untuk sampel pangan, lingkungan (red. swab), maupun rectal dari operator yang menangani makanan tersebut. Hal ini membuat penggunaan media RAPID’Salmonella agar ini selain untuk sampel bahan makanan maupun makanan siap saji yang telah dibuat, media ini juga dapat dipergunakan untuk mengujikan sampel-sampel dari hasil swab peralatan dapur maupun swab rectal dari para operator yang bekerja di dapur pembuatan makanan tersebut.
Gambar 4 Hasil Pengujian Pada Media RAPID’Salmonella Agar
Nah setelah membaca penjelasan di atas terkait media RAPID’Salmonella agar dalam hal perananannya sebagai satpam yang mendeteksi keberadaan cemaran Salmonella spp. agar tidak ikut terbawa pada sampel makanan MBG menjadikan program MBG ini lebih aman dari cemaran bakteri Salmonella spp. dan bisa menghindari kasus keracunan makanan terutama yang dikarenakan oleh bakteri Salmonella. Bagi para penyedia media mikrobiologi untuk lini pemerintahan, media RAPID’Salmonella agar ini juga sudah tersedia di e-katalog loh.
Baca Juga: Membrane Filtration (MF) solusi untuk Enumerasi Mikroba pada Sampel Air
Di penghujung cerita bulletin kita ini, yuk kita coba rekap beberapa manfaat/fitur dari media RAPID’Salmonella ini sehingga layak dijadikan satpam dalam isu keamanan pangan baik di program MBG maupun dalam pengujian keamanan pangan disetiap Laboratorium mikrobiologi baik di industri dan lab pengujian baik swasta maupun pemerintahan:
- Tervalidasi terhadap ISO 16140-2 atas referensi metode ISO 6579-1
- Memiliki sertifikasi internasional dari AOAC, AFNOR, maupun NordVal
- Bisa diimplementasikan untuk akreditasi laboratorium uji ISO 17025
- Waktu pengerjaan yang relatif singkat, hanya membutuhkan 2 hari saja
- Interpretasi hasil yang mudah, koloni Salmonella spp. berwarna magenta
- Waktu uji konfirmasi yang relative singkat, kurang dari 5 menit saja
- Tervalidasi atas sampel pangan, pakan, lingkungan, dan rectal
Bagaimana? Menarikan kan Buletin Warung Sciencewerke-nya?
Sebagai penutup, solusi media kromogenik dari BioRad Laboratories bukan hanya RAPID’Salmonella saja loh. Masih banyak solusi-solusi media RAPID Kromogenik untuk parameter lainnya yang mungkin dibutuhkan seperti E.coli/Coliform, Staphylococcus aureus, Enterobacteriaceae, Listeria monocytogenes, dsb. Tungguin aja informasi-informasi berikutnya di Buletin Warung Sciencewerke lainnya ya. Sampai ketemu lagi di tulisan berikutnya. Bye-bye… ☺
Informasi Terkait:
- Manual Guide; RAPID’Salmonella Agar
- MSDS; RAPID’Salmonella Agar
- Sertifikat dan Laporan Validasi; AOAC
- Sertifikat dan Laporan Validasi; AFNOR (NF Validation)
- Sertifikat dan Laporan Validasi; NordVal
Order here: https://wa.me/6285888800005
Mari Terhubung dengan Kami
Telepon Kantor : 021 5366 7591
Email : [email protected]
WhatsApp : 0858 8880 0005
Kunjungi media sosial Offical Sciencewerke:
Instagram: @sciencewerke_id
Linkedin: PT Sciencewerke
X : Sciencewerke ID
Youtube: PT Sciencewerke